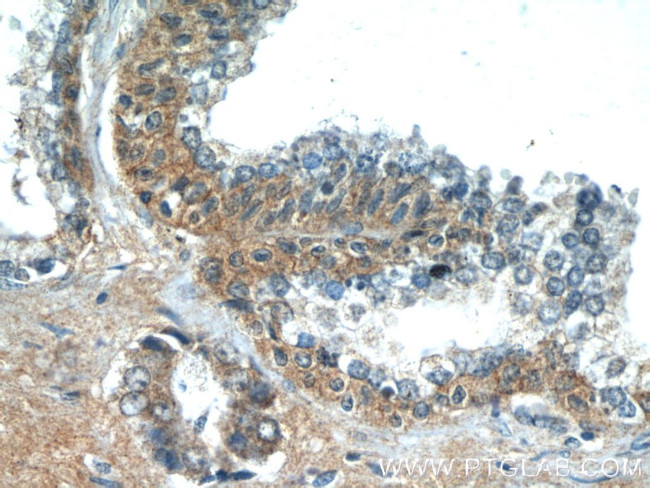
LZTS2 Antibody in Immunohistochemistry (Paraffin) (IHC (P))
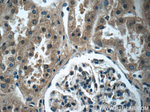
LZTS2 Antibody in Immunohistochemistry (Paraffin) (IHC (P))
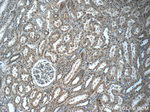
LZTS2 Antibody in Immunohistochemistry (Paraffin) (IHC (P))

Search
Proteintech
LZTS2 Polyclonal Antibody
{{$productOrderCtrl.translations['antibody.pdp.commerceCard.promotion.promotions']}}
{{$productOrderCtrl.translations['antibody.pdp.commerceCard.promotion.viewpromo']}}
{{$productOrderCtrl.translations['antibody.pdp.commerceCard.promotion.promocode']}}: {{promo.promoCode}} {{promo.promoTitle}} {{promo.promoDescription}}. {{$productOrderCtrl.translations['antibody.pdp.commerceCard.promotion.learnmore']}}
产品信息
15677-1-AP
种属反应
已发表种属
宿主/亚型
分类
类型
抗原
偶联物
形式
浓度
规格
纯化类型
保存液
内含物
保存条件
运输条件
产品详细信息
Immunogen sequence: PSDEALLHC VLEGKLRDRE AELQQLRDSL DENEATMCQA YEERQRHWQR EREALREDCA AQAQRAQRAQ QLLQLQVFQL QQEKRQLQDD FAQLLQEREQ LERRCATLER EQRELGPRLE ETKWEVCQKS GEISLLKQQL KESQAELVQK GSELVALRVA LREARATLRV SEGRARGLQE AARARELELE ACSQELQRHR QEAEQLREKA GQLDAEAAGL REPPVPPATA DPFLLAESDE AKVQRAAAGV GGSLRAQVER LRVELQRERR RGEEQRDSFE GERLAWQAEK EQVIRYQKQL QHNYIQMYRR NRQLEQELQQ LSLELEAREL ADLGLAEQAP CICLEEITAT EI (319-669 aa encoded by BC006212)
靶标信息
LZTS2 is a negative regulator of katanin-mediated microtubule severing and release from the centrosome. LZTS2 is required for central spindle formation and the completion of cytokinesis.
仅用于科研。不用于诊断过程。未经明确授权不得转售。
生物信息学
蛋白别名: hLZTS2; Leucine zipper putative tumor suppressor 2; leucine zipper, putative tumor suppressor 2; Protein LAPSER1; putative tumor suppressor LAPSER1; RP11-108L7.8; unnamed protein product
基因别名: BC014695; KIAA1813; LAPSER1; LZTS2; mKIAA1813
UniProt ID: (Human) Q9BRK4, (Mouse) Q91YU6
Entrez Gene ID: (Human) 84445, (Mouse) 226154